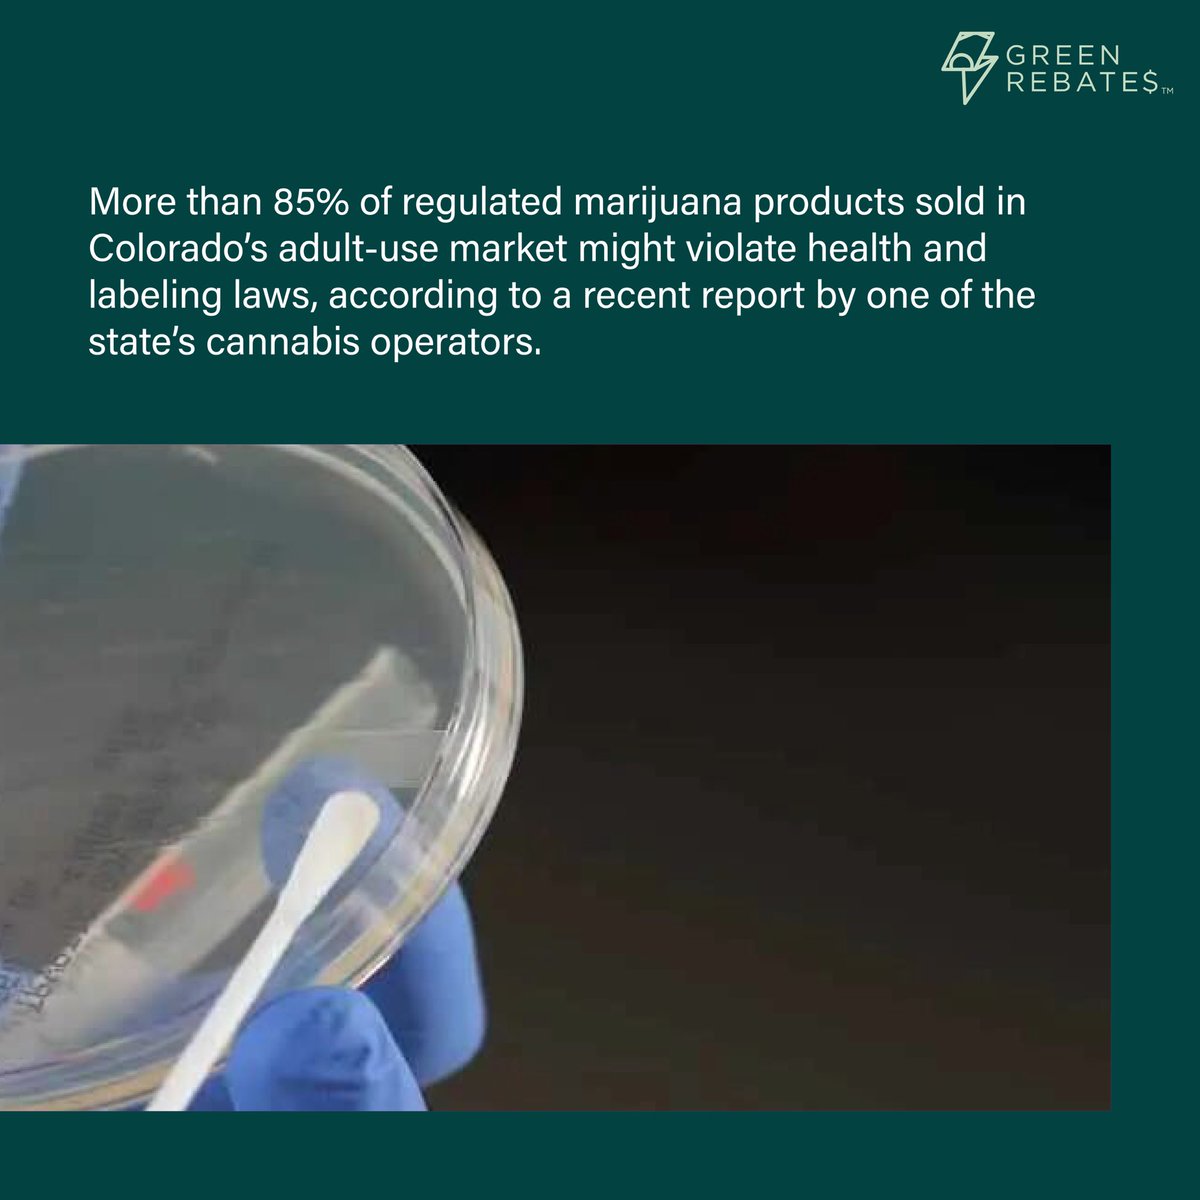
More than 85% of regulated products in Colorado’s adult-use market may not meet health and labeling standards, according to a recent report from Colorado-based company Ripple.

Read the full story at the link in our bio 🔗

#CannabisNews #ColoradoCannabis #HealthAndSafety

Green Rebates
@greenrebates1
GROW GREEN|SAVE GREEN|GREEN REBATES 🌿 Serving the Horticulture Industry 💸 Over $50 mil in Rebates Secured 💡 Get LEDS & HVAC at no cost to you!
ID: 1856751561541869568
http://greenrebates.com 13-11-2024 17:30:57
68 Tweet
9 Followers
11 Following

















Minneapolis here we come! Who else is hitting the Twin Cities this weekend? The LuckyLeafExpo starts tomorrow, where Green Rebates will be filming live episodes of the Money Talks podcast, educating folks rebates, and giving away FREE MONEY. Come say hi at booth 203


Knowledge was dropped at LuckyLeafExpo last weekend. It’s never too early to start the rebate process, but often times it’s too late. Hit us up before purchasing your facility so we can guide you in the direction of Free Money!